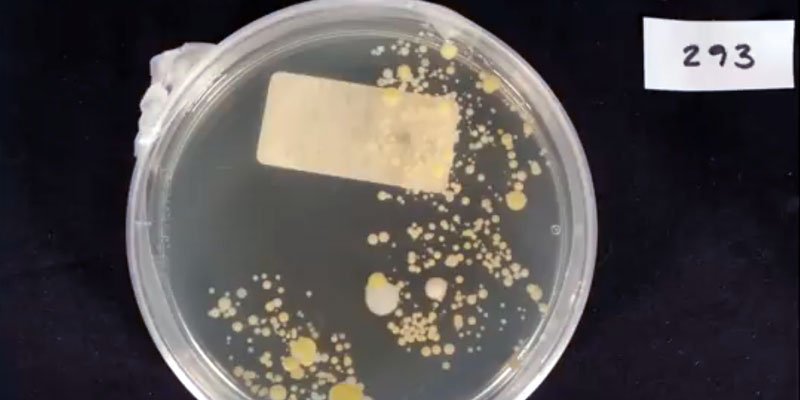

Udstilling om tarmbakterier vinder Udstillingsprisen Vision 2015
Medicinsk Museions udstillingskoncept med titlen Mind the Gut er nu udpeget som vinder af Udstillingsprisen Vision 2015. Museet modtager dermed 3 mio. kr. til at realisere udstillingen.
Medicinsk Museions udstillingskoncept med titlen Mind the Gut er nu udpeget som vinder af Udstillingsprisen Vision 2015. Museet modtager dermed 3 mio. kr. til at realisere udstillingen.
En enstemmig jury har nu valgt Medicinsk Museions tankevækkende udstillingskoncept Mind the Gut som vinder af Udstillingsprisen Vision 2015. 46 museer og udstillingssteder inden for det kunst- og kulturhistoriske felt har deltaget i Bikubenfondens nye konkurrence om at vinde 3 mio. kr. til realisering af et nyskabende og visionært udstillingskoncept.
På vegne af juryen for Udstillingsprisen Vision udtaler Bikubenfondens projektchef Mette Marcus følgende som motivation for valget af Mind the Gut:
”Idéen om at ville samtænke præsentationen af ny viden med et æstetisk og sansemættet formidlingsgreb er et visionært bud på at skabe et anderledes refleksionsrum. Der er en aktuel relevans i udstillingsidéen i forhold til at ville præsentere den seneste forskning vedrørende betydningen af mavens bakterier for hjernen, og samtidig synliggøre det særlige felt inden for samtidskunsten, som bio art udgør. Vi anser Mind the Gut for at være en nytænkende udstillingsidé og ser frem til, at den realiseres i foråret 2017.”
”Jeg synes det er meget visionært af fonden at give prisen til et udstillingskoncept som overskrider den fasttømrede opdeling mellem kulturhistoriske, naturhistoriske og kunstmuseer som museumsverdenen traditionelt opererer med. Vi bliver nødt til at arbejde på tværs af de kategorier for at videreudvikle museerne”, siger museumschef og professor Thomas Söderqvist, Medicinsk Museion.

Mind the Gut tager udgangspunkt i aktuel biomedicinsk forskning i sammenhængen mellem hjernen, maven og de bogstaveligt talt trillioner af bakterier og andre mikroorganismer, der lever i tarmsystemet.
I de seneste fem år har forskningen vist, at bakterierne i langt større grad, end man hidtil havde forestillet sig, påvirker vores sundhedstilstand og velbefindende. Bliver vores identitet til i en vekselvirkning mellem os og bakterierne, spørger udstillingen. Måske skal vi ikke længere spørge “hvem er jeg?”, men “hvem er vi?”
Mind the Gut vil løfte forskningsformidling ud af en traditionel snævert didaktisk og nyhedsfokuseret ramme for at skabe rum til æstetisk og kulturel refleksion samt plads til samtale. De forskelligartede perspektiver på forskningen vil blive bundet sammen af et fokus på sanselighed. Kunstværker, kulturarv og videnskabelige genstande vil blive udstillet på måder, der sætter gang i hørelsen samt lugte-, føle-, syns- og smagssansen.
Debat om den gode udstilling
Det er et meget stærkt men også bredt felt af konkurrencedeltagere, der har dystet om at modtage Udstillingsprisen Vision 2015 – både geografisk og tematisk. Dog er enkelte tematikker gået igen, herunder et fokus på krop og køn, sociale problemstillinger, det offentlige rum som udstillingsplatform samt publikumsinddragelse.
Bikubenfondens overordnede mål på kulturområdet er at bidrage til at højne kvaliteten af kunst og kultur i Danmark, herunder også formidlingen af den. Derfor er hovedformålet med den nye konkurrence at bakke op om det særlige formidlingsgreb, udstillinger er. Formålet er desuden at skabe en debat om, hvad der kendetegner en god udstilling. Dette spørgsmål vil blandt andet være på dagsordenen, når Bikubenfonden i samarbejde med Kunsten.nu arrangerer en debat under Copenhagen Art Week senere på året.
”Det geniale ved denne pris er, at den ikke er bagud skuende, men inspirerer modtageren til at tænke fremadrettet. Selv om vi har arbejdet på grænsefladen mellem kunst, kultur og videnskab igennem de sidste ti år, så har vi nu fået et gevaldigt incitament til at bringe integrationen mellem kunst, kultur og videnskab et skridt videre”, siger museumschef og professor Thomas Söderqvist, Medicinsk Museion.
Fakta
Pris
Udstillingsprisen Vision
Fakta
Om Udstillingsprisen Vision:
Udstillingsprisen Vision uddeles én gang om året.
Kriterierne for at vinde prisen er: en visionær og nyskabende udstillingsidé med aktuel relevans, der giver publikum indsigt og udsyn.
Vinderen modtager prisen på 3 mio. kr. til realisering af en udstilling. Såfremt udstillingsbudgettet er større, kan fonden vælge at give et større beløb, så det samlede udstillingsbudget dækkes.
Udstillingen skal senest åbne inden for tre år efter prisoverrækkelsen, dvs. senest i 2017.
Juryen for Udstillingsprisen Vision består af:
- Rune Gade, lektor, ph.d. ved Institut for Kunst- og Kulturvidenskab og anmelder ved Dagbladet Information.
- Niels-Knud Liebgott, historiker og tidl. direktør for De Danske Kongers Kronologiske Samling på Rosenborg Slot.
- Mette Kynne Frandsen, adm. direktør, partner og arkitekt MAA, Henning Larsen Architects
- Mads Quistgaard, adjungeret professor ved Designskolen Kolding
- Stine Goya, designer
- Søren Kaare-Andersen, direktør i Bikubenfonden
- Mette Marcus, projektchef i Bikubenfonden
Bikubenfonden samarbejder med kunsten.nu om Udstillingsprisen Vision.
Læs mere om Udstillingsprisen Vision her.